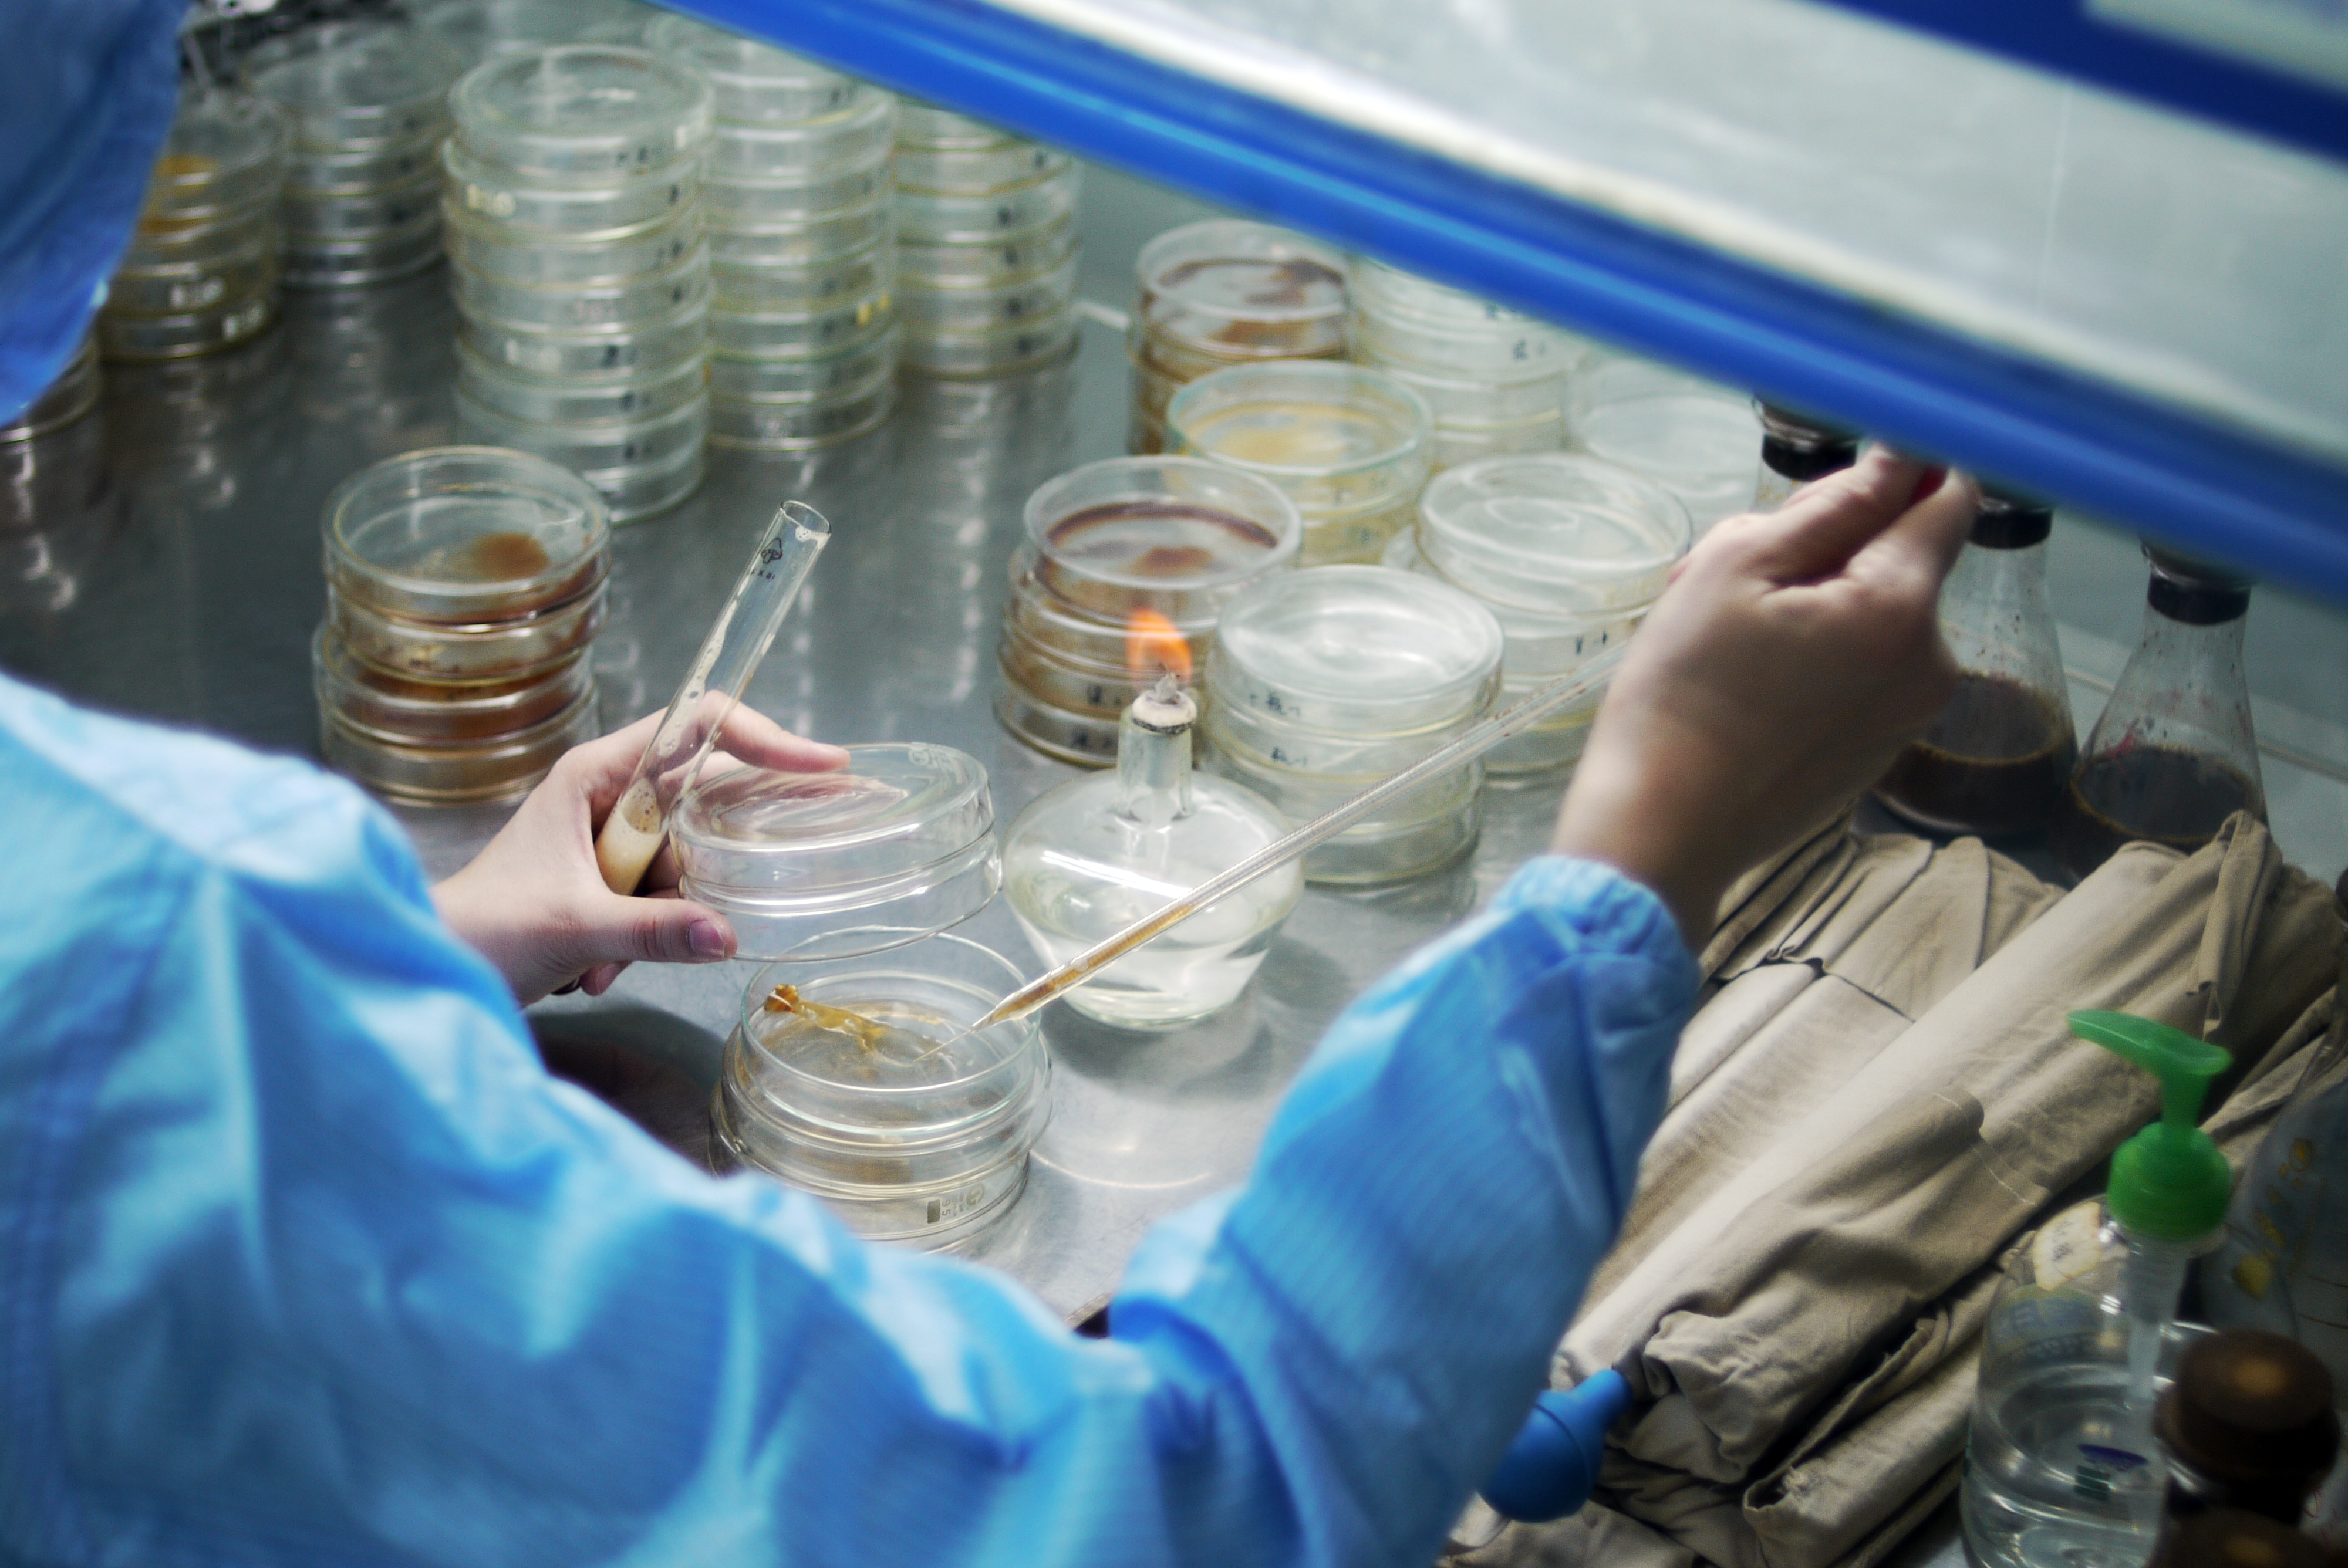

【診療配藥化繁為簡】中藥現代化加速來臨!立即了解免煎煮配方顆粒
中醫作為世界上最古老的醫學之一,擁有超過2000年的歷史,現時為世界上25%的人口提供基礎醫療。不少人對中醫的印象仍停留在「望聞問切」、開藥方、配藥材、細火慢煲後才可飲用的傳統繁文縟節流程中,事實上隨著時代的進步,中醫診症、配藥的流程已經大大化繁為簡,農本方®更結合現代及電子化技術,為都市人提供便捷而且具效率的中醫服務!

力求創新開創先河 成中藥配方顆粒的佼佼者
隨著人類的健康意識不斷提升,農本方®在母公司培力控股有限公司的支持下,近年致力推行中醫藥現代化,由中藥材種植、研究開發、中藥配方顆粒、保健養生產品、農本方®中醫診所勻能提供一條龍服務!

傳統中草藥種類繁多,部分中草藥的供應更是「一藥難求」,加上傳統煎藥必須細火慢熬,對忙碌的港人而言,是極之花時間的步驟。有見及此,農本方®力求創新,採用「尖端動態提取技術」,以低溫濃縮提取傳統中草藥的精粹,保留原藥材的活性成分,鑄造出時下廣為人認識的濃縮中藥配方顆粒!
農本方®濃縮中藥顆粒已有10多年歷史,由科研、種植、煎煮、濃縮、包裝等各個步驟都為一體化,由内部嚴密監控;目前擁有超過700種濃縮配方顆粒,不但方便極致,能免卻煎煮藥的繁複,旗下之複方濃縮中藥顆粒、非處方藥(OTC產品)及部份單味濃縮中藥顆粒均已在香港註冊,亦受GMP標準認可及通過農藥殘留、重金屬、微生物的國 際標準檢驗,具有品質保證!現時已獲香港多間中醫診所採用,並多年來為政府中醫診所提供中藥濃縮顆粒,成為全港濃縮中藥配方顆粒的供應商,方便港人服用!

自設草藥種植基地及種子種苗繁育中心 醫病保健一應俱全
為求生產出高品質的產品,品牌對收集原藥材及生產過程的要求亦相當之高!在中國特設自家草藥種植基地及種子種苗繁育國家工程中心,堅持以種子種苗,配合先進植物繁殖技術,確保原藥材有優越的品質及穩定的供應量。而所收集得到的原藥材,之後會送往自家的現代化工廠,以先進設備及高標準、高精準技術,經過清洗、提取、濃縮、乾燥、製粒、包裝等處理工序,嚴格監控各個步驟及品質,成為濃縮中藥配方顆粒!

傳統中醫理念揉合智能、AI技術 現代化中醫診所 上網診症即將推出
時下都市人習慣有病才求診,然而在中醫角度,日常就應該多加調理保健,讓身體盡量處於平衡狀態,減少疾病的出現!農本方®中醫診所作為全港最大中醫診所連鎖集團,擁有約30家中醫診所,地點遍佈港九新界。其應診之中醫師均為專業註冊中醫師及具有多年中醫診症及臨床經驗,可提供診症、配藥、針灸、拔罐、敷藥等服務!


農本方®中醫診所另外更擁有一套獨特而完善的「農本方®智能中醫診所管理及配藥系統」,由病人登記、醫療記錄整理、醫師診斷、擬定處方、存貨管理,以至濃縮配方顆粒產品處方的調配都採用現代化科學管理,病歷紀錄更全面電子化,方便醫師追溯配藥記錄,同時亦方便病人因應自己行程到不同門市求症,相較傳統中醫單一門市診症先進及便利得多!

在標準化的操作流程之上,農本方®中醫診所更應用AI技術自主研發及診斷程序,並即將推出視像診症服務,患者無須到門市即可診症,適合患輕症或需要長期調理的港人,藥物之後會以速遞形式送到府上或指定地點。
此外,農本方®亦備有為保健養生而研發的中藥保健產品及藥用治療的沖劑,包括:金靈芝、黑目瞳、安固生雲芝膠囊、止嗽散、複方羅漢果止咳沖劑等,助港人作全身保健及預防疾病之用。


Featured For Nong’s



